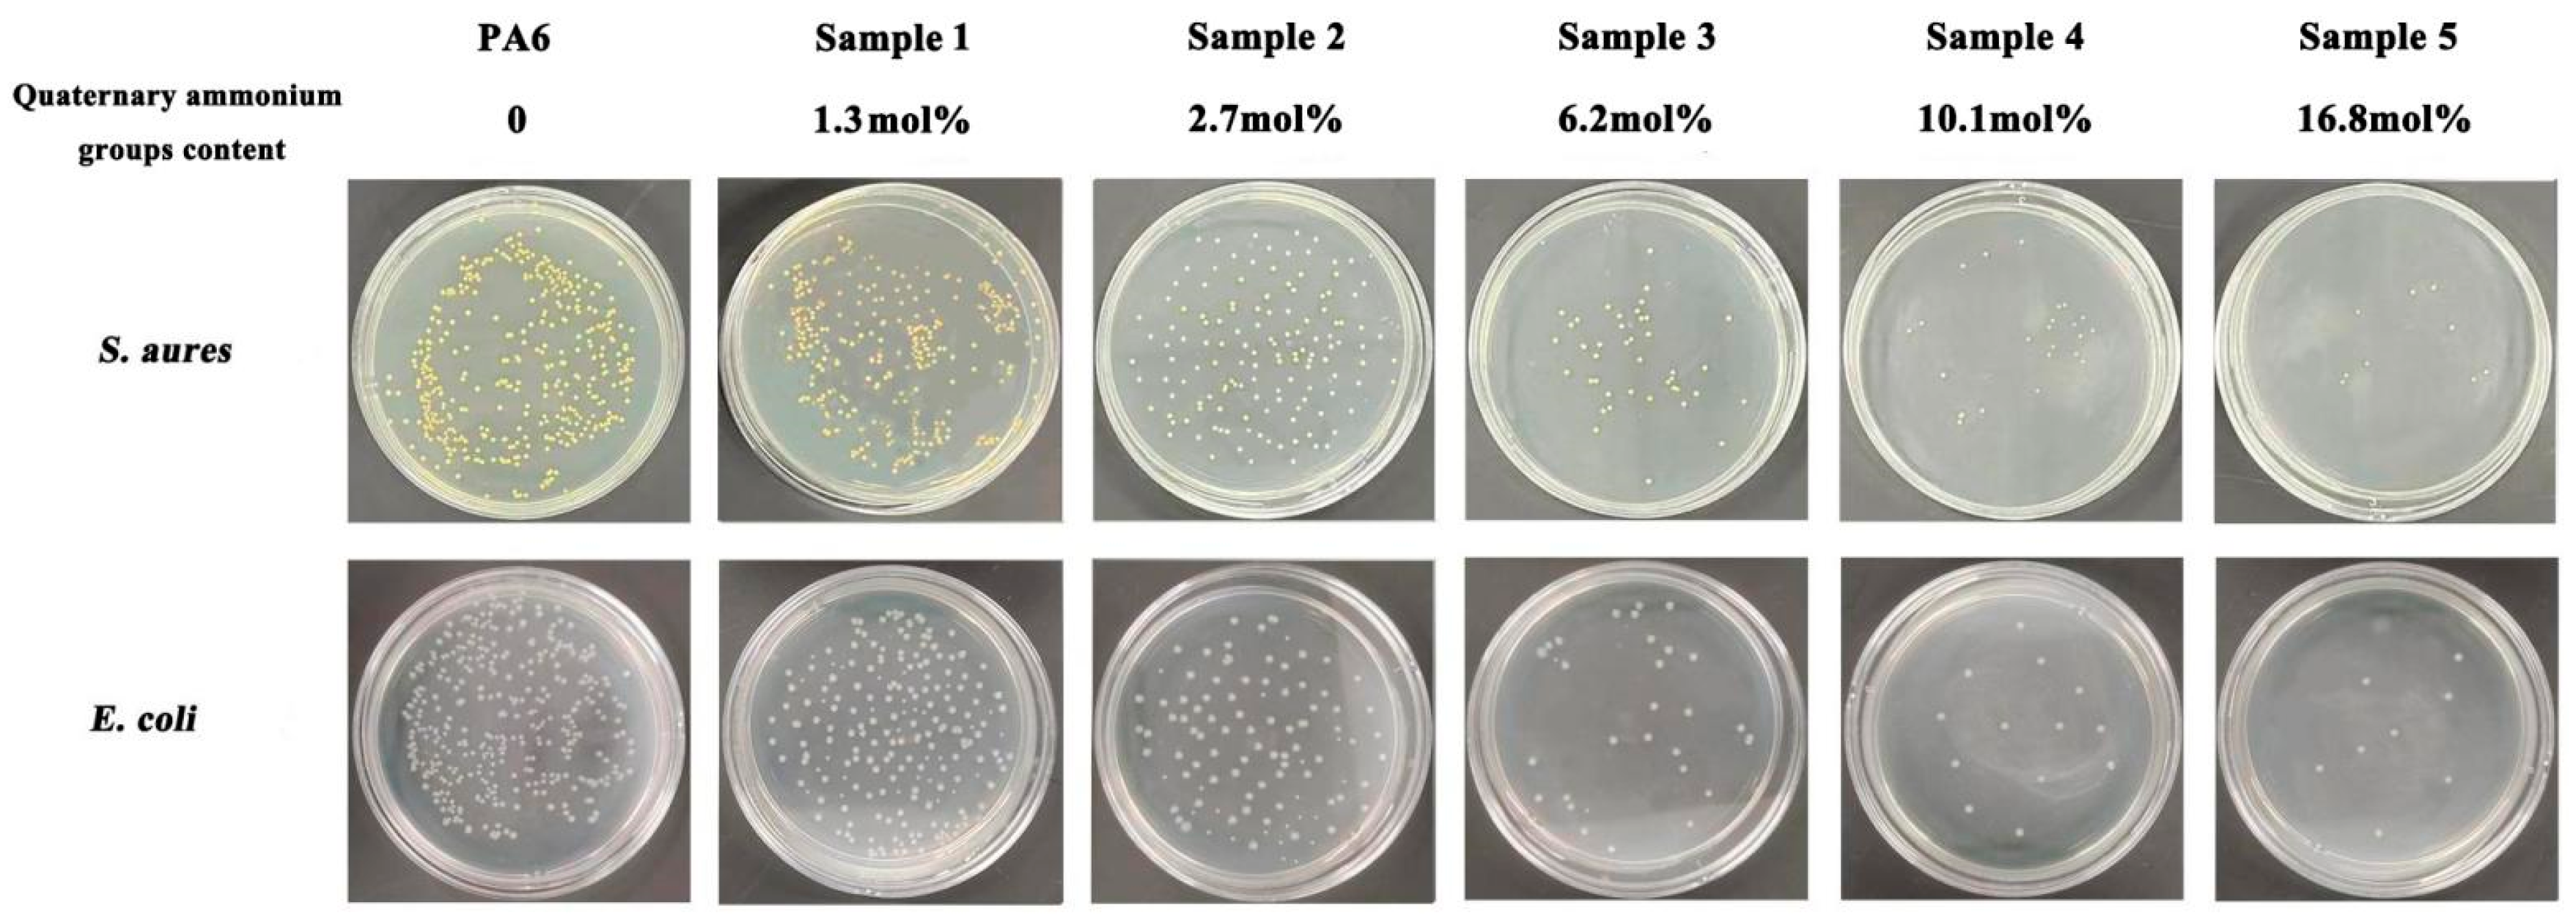
Polymers 16 01997 g009

Preparation of an Antibacterial Branched Polyamide 6 via Hydrolytic Ring-Opening Co-Polymerization of ε-Caprolactam and Lysine Derivative
Abstract
1. Introduction
2. Materials and Methods
2.1. Materials
2.2. Co-Polymerization
2.3. Quaternization of the Co-Polymers
2.4. Characterization and Test of Properties
2.5. Antimicrobial Activities Test of Co-Polymers after Quaternization
3. Results
3.1. The Reaction Mechanism of Co-Polymerization
3.2. The Structure Characterization of the Co-Polymers
3.3. Monomer Conversion, Configuration and Incorporation of the Co-Polymers
3.4. Rheological Properties Test of Co-Polymers with Different ACL Feed
3.5. Mechanical Properties of the Co-Polymers
3.6. Quaternization of the Co-Polymers
3.7. Thermal Properties Test of Co-Polymers with Different Quaternary Ammonium Groups Incorporated
3.8. Antibacterial Activities Test of Co-Polymers
4. Conclusions
Author Contributions
Funding
Institutional Review Board Statement
Data Availability Statement
Acknowledgments
Conflicts of Interest
References
- Kudo, H.; Buya, K. Mechanistic Study of Ring-Opening Copolymerization of ε-caprolactam with epoxide: Development of novel thermosetting epoxy resin system. J. Polym. Sci. Part A Polym. Chem. 2016, 54, 2220–2228. [Google Scholar] [CrossRef]
- Gong, Y.; Liu, A.; Yang, G. Polyamide single polymer composites prepared via insitu anionic polymerization of ε-caprolactam. Compos. Part. A Appl. Sci. Manuf. 2010, 41, 1006–1011. [Google Scholar] [CrossRef]
- Naumann, S.; Epple, S.; Bonten, C.; Buchmeiser, M.R. Polymerization of ε-Caprolactam by Latent Precatalysts Based on Protected N-Heterocyclic Carbenes. ACS Macro Lett. 2013, 2, 609–612. [Google Scholar] [CrossRef] [PubMed]
- Hashimoto, K. Ring-opening polymerization of lactams. Living anionic polymerization and its applications. Prog. Polym. Sci. 2000, 25, 1411–1462. [Google Scholar] [CrossRef]
- Wang, J.; Kuai, P.; Liu, H.; Feng, Z. Development Status of Nylon 6 and Nylon 66 in China. Synth. Fiber China 2021, 50, 8–11. [Google Scholar]
- Kumaran, S.; Han, S.; Choi, H. Photopolymerizable, Universal Antimicrobial Coating to Produce High-Performing, Multifunctional Face Masks. Nano Lett. 2021, 21, 5422–5429. [Google Scholar] [CrossRef] [PubMed]
- Zhou, J.; Zabihi, F.; Chen, Z.; Zhu, M. Progress and Perspective of Antiviral Protective Material. Adv. Fiber. Mater. 2020, 2, 123–139. [Google Scholar] [CrossRef] [PubMed]
- Ulery, B.D.; Nair, L.S.; Laurencin, C.T. Biomedical applications of biodegradable polymers. J. Polym. Sci. Part B Polym. Phys. 2011, 49, 832–864. [Google Scholar] [CrossRef]
- Hernández-Escolano, M.; Juan-Díaz, M.; Martínez-Ibáñez, M.; Jimenez-Morales, A.; Goñi, I.; Gurruchaga, M. The design and characterisation of sol gel coatings for the controlled-release of active molecules. J. Sol-Gel Sci. Technol. 2012, 64, 442–451. [Google Scholar] [CrossRef]
- Tang, W.; Xiao, W.; Ye, E.; Liao, J. Discussion on the anti-microbe fabrics. Chem. Fiber Text. Technol. 2003, 004, 28–35. [Google Scholar]
- Erem, A.D.; Ozcan, G.; Skrifvars, M.; Cakmak, M. In vitro assesment of antimicrobial activity and characteristics of polyamide 6/silver nanocomposite fibers. Fibers Polym. 2013, 14, 1415–1421. [Google Scholar] [CrossRef]
- Bucheńska, J. Polyamide fibers (PA6) with antibacterial propertie. J. Appl. Polym. Sci. 1996, 61, 567–576. [Google Scholar] [CrossRef]
- Shi, Z. Grafting chitosan oxidized by potassium persulfate onto Nylon 6 fiber, and characterizing the antibacterial property of the graft. J. Polym. Res. 2014, 21, 534–539. [Google Scholar] [CrossRef]
- Tao, Z.; Kang, H. Enhancement of the Processability and Properties of Nylon 6 by Blending with Polyketone. Polymers 2021, 13, 3403. [Google Scholar] [CrossRef]
- Lian, J.; Chen, J.; Luan, S.; Liu, W.; Zong, B.; Tao, Y.; Wang, X. Organocatalytic Copolymerization of Cyclic Lysine Derivative and ε-Caprolactam toward Antibacterial Nylon-6 Polymers. ACS Macro Lett. 2022, 11, 46–52. [Google Scholar] [CrossRef]
- Liu, K.; Shao, B.; Liu, H.; He, J.; Zheng, A.; Li, G.; Zheng, B.; Li, Z.; Liu, W.; Li, X.; et al. Sustainable production of dimethyl-protected cyclic lysine over Pd/m-Al2O3-Si catalysts and its application in synthesis of antibacterial nylon6 copolymers. Chem. Eng. J. 2023, 463, 142504. [Google Scholar] [CrossRef]
- Kohan, M.I. Nylon Plastics Handbook; Hanser: New York, NY, USA, 1995; pp. 112–118. [Google Scholar]
- Galleny, P.G. Nylon 6. In Polymer Data Handbook; Mark, J.E., Ed.; Oxford University Press: New York, NY, USA, 1999; pp. 180–185. [Google Scholar]
- ASTM D638; Standard Test Method for Tensile Properties of Plastics. ASTM International: West Conshohocken, PA, USA, 2022.
- GB/T 31402-2015; Plastics—Measurement of antibacterial activity on plastics surfaces. Standardization Administration of China: Beijing, China, 2015.
- Sugimoto, M.; Tanaka, T.; Masubuch, Y. Effect of chain structure on the melt rheology of modified polypropylene. J. Appl. Polym. Sci. 1999, 73, 1493–1500. [Google Scholar] [CrossRef]
- Kima, H.; Oha, K.; Seo, Y. Rheological and mechanical properties of a novel polyamide 6 synthesized by anionic polymerization of ε-caprolactam in a twin-screw extruder. Polymer 2019, 177, 196–201. [Google Scholar] [CrossRef]
- Seo, Y.P. Effect of molecular structure change on the melt rheological properties of a polyamide (nylon 6). ACS Omega 2018, 12, 16549–16555. [Google Scholar] [CrossRef]
- Doi, M. Explanation for the 3.4-power law for viscosity of polymeric liquids on the basis of the tube model. J. Polym. Sci. B 1983, 21, 667–684. [Google Scholar] [CrossRef]
- Young, R.J.; Lovell, P.A. Introduction to Polymers; CRC Press: Boca Raton, FL, USA, 2011; p. 263. [Google Scholar]
- Gotsis, A.D.; Zeevenhoven, B.L.F.; Tsenoglou, C. Effect of long branches on the rheology of polypropylene. J. Rheol. 2004, 48, 895–914. [Google Scholar] [CrossRef]
- Ruymbeke, E.; Stephenne, V.; Daoust, D. A sensitive method to detect very low levels of long chain branching from the molar mass distribution and linear viscoelastic response. J. Rheol. 2005, 49, 1503–1520. [Google Scholar] [CrossRef]
- Núñez, E.; Ferrando, C.; Malmström, E.; Claesson, H.; Gedde, U.W. Crystallization behavior and morphology of star polyesters with poly (ε-caprolactone) arms. J. Macromol. Sci. B 2004, 43, 1143–1160. [Google Scholar] [CrossRef]
- Timofeeva, L.; Kleshcheva, N. Antimicrobial polymers: Mechanism of action, factors of activity, and applications. Appl. Microbiol. Biotechnol. 2011, 89, 475–492. [Google Scholar] [CrossRef]

| Entry | Feed ACL/DMCL/CPL | ηr | Mw | Conversion(%) ACL/DMCL/CPL | Incorporation ACL/DMCL/CPL |
|---|---|---|---|---|---|
| 1 | 0/0/100 | 2.63 | 17010 | 0/91.2 | - |
| 2 | 1/4/95 | 2.51 | 15850 | 35.7/33.4/92.1 | 0.4/1.6/98 |
| 3 | 1/8/91 | 2.49 | 15640 | 35.3/36.2/91.1 | 0.4/3.4/96.2 |
| 4 | 1/13/86 | 2.42 | 14910 | 35.9/41.2/91.2 | 0.5/7.4/92.1 |
| 5 | 1/22/77 | 2.20 | 12610 | 34.8/47.3/90.9 | 0.4/12.8/86.8 |
| 6 | 1/30/69 | 1.98 | 10290 | 33.7/54.1/90.2 | 0.4/20.7/78.9 |
| 7 | 1/50/49 | 1.89 | 9340 | 34.1/63.2/91.4 | 0.4/37.4/62.2 |
| 8 | 1/70/29 | 1.42 | 4410 | 33.1/75.1/90.2 | 0.3/49.9/49.8 |
| Entry | Feed ACL/DMCL/CPL | ηr | Mw | Zero Shear Viscosity (Pa·s) | Melt Index |
|---|---|---|---|---|---|
| 1 | 0/13/87 | 2.31 | 13780 | 405 | 71.4 |
| 2 | 0.5/13/86.5 | 2.40 | 14470 | 20542 | 251 |
| 3 | 1/13/86 | 2.42 | 14910 | 31454 | 279 |
| 4 | 2/13/85 | 2.38 | 14510 | 49523 | 386 |
| Sample | Feed ACL/DMCL/CPL | Incorporation DMCL Content | Quaternization Rate (%) | Quaternary Ammonium Groups Incorporated (%) |
|---|---|---|---|---|
| 1 | 1/4/95 | 1.6 | 80.2 | 1.3 |
| 2 | 1/8/91 | 3.4 | 80.9 | 2.7 |
| 3 | 1/15/84 | 7.4 | 81.9 | 6.2 |
| 4 | 1/22/77 | 12.8 | 79.7 | 10.1 |
| 5 | 1/30/69 | 20.7 | 81.2 | 16.8 |
| 6 | 1/50/49 | 37.4 | 80.1 | 30.2 |
| The Polymer | Quaternary Ammonium Groups Incorporated (%) | Melting Point (°C) | Crystallinity (%) | Initial Thermal Degradation Temperature (°C) | Maximum-Rate Thermal Degradation Temperature (°C) |
|---|---|---|---|---|---|
| PA6 | 0 | 221.2 | 27.38 | 424.4 | 458.1 |
| Sample 1 | 1.3 | 211.4 | 25.59 | 414.2 | 456.2 |
| Sample 2 | 2.7 | 209.8 | 24.26 | 401.2 | 453.1 |
| Sample 3 | 6.2 | 201.4 | 22.32 | 398.4 | 451.9 |
| Sample 4 | 10.1 | 189.2 | 20.19 | 382.2 | 450.7 |
| Sample 5 | 16.8 | 168.4 | 18.20 | 361.1 | 449.2 |
| Sample 6 | 30.2 | - | - | 283.4 | 398.6 |
Disclaimer/Publisher’s Note: The statements, opinions and data contained in all publications are solely those of the individual author(s) and contributor(s) and not of MDPI and/or the editor(s). MDPI and/or the editor(s) disclaim responsibility for any injury to people or property resulting from any ideas, methods, instructions or products referred to in the content. |
© 2024 by the authors. Licensee MDPI, Basel, Switzerland. This article is an open access article distributed under the terms and conditions of the Creative Commons Attribution (CC BY) license (https://creativecommons.org/licenses/by/4.0/).
Share and Cite
Mao, X.; Liu, W.; Li, Z.; Mei, S.; Zong, B. Preparation of an Antibacterial Branched Polyamide 6 via Hydrolytic Ring-Opening Co-Polymerization of ε-Caprolactam and Lysine Derivative. Polymers 2024, 16, 1997. https://doi.org/10.3390/polym16141997
Mao X, Liu W, Li Z, Mei S, Zong B. Preparation of an Antibacterial Branched Polyamide 6 via Hydrolytic Ring-Opening Co-Polymerization of ε-Caprolactam and Lysine Derivative. Polymers. 2024; 16(14):1997. https://doi.org/10.3390/polym16141997
Chicago/Turabian StyleMao, Xiaoyu, Wei Liu, Zeyang Li, Shan Mei, and Baoning Zong. 2024. "Preparation of an Antibacterial Branched Polyamide 6 via Hydrolytic Ring-Opening Co-Polymerization of ε-Caprolactam and Lysine Derivative" Polymers 16, no. 14: 1997. https://doi.org/10.3390/polym16141997
APA StyleMao, X., Liu, W., Li, Z., Mei, S., & Zong, B. (2024). Preparation of an Antibacterial Branched Polyamide 6 via Hydrolytic Ring-Opening Co-Polymerization of ε-Caprolactam and Lysine Derivative. Polymers, 16(14), 1997. https://doi.org/10.3390/polym16141997
